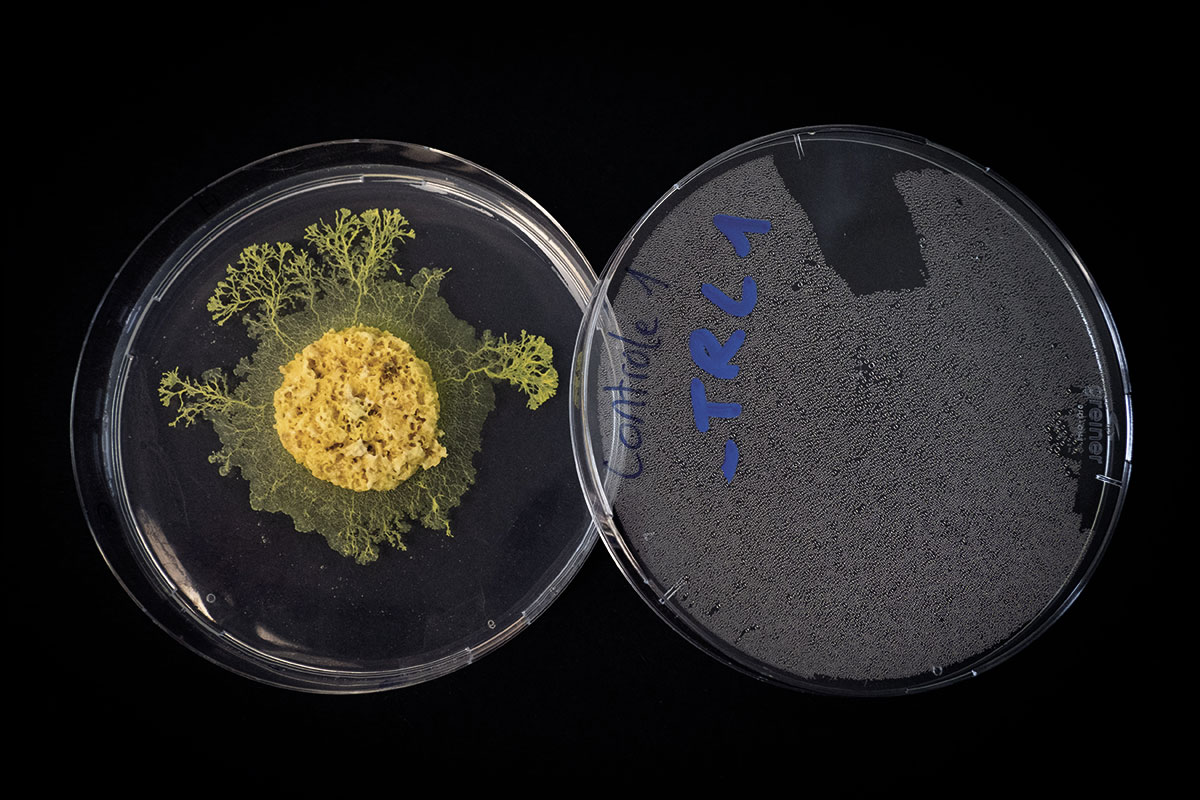

Photo: David VILLA/ScienceImage, CBI/CRCA/CNRS Photothèque
Le temps d’une expérience de science participative, notre journaliste a accueilli chez elle un blob, un organisme qui fascine autant les scientifiques que les profanes.
Contrairement à un chaton ou à un chiot à la bouille attendrissante, cette petite créature jaune d’apparence spongieuse ne possède aucun charme pouvant susciter l’affection. Pourtant, plus de 14 000 personnes, dont moi, ont souhaité accueillir ce fascinant « animal » de compagnie ces derniers mois : le blob !
À l’automne 2021, la chercheuse française Audrey Dussutour et son équipe du Centre national de la recherche scientifique (CNRS) conviaient des volontaires à se prêter au jeu de la science participative avec le projet Derrière le blob, la recherche. Les candidats et candi- dates se sont inscrits en masse ! Est-ce le séjour d’un blob dans la Station spatiale internationale qui a suscité un intérêt pour ce type d’organisme ? En 2021, l’astronaute français Thomas Pesquet a mené une expérience avec un spécimen surnommé Blobi Wan Kenobi, clin d’œil à La guerre des étoiles, tandis que des milliers d’écoles françaises effectuaient les mêmes manipulations scientifiques dans leurs classes, sur Terre.
Qu’est-ce que le blob, au fait ? Il s’agit d’un myxomycète qui décompose la matière organique du sol des forêts partout à travers le monde.








